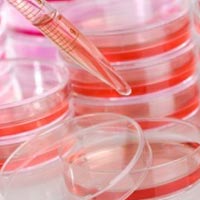

Ученые назвали 6 вещей, провоцирующих рак
Онкологические заболевания являются одними из самых страшных во всем мире, которые ежегодно подписывают миллионам людей во всем мире смертный приговор. Именно поэтому важ

Учеными обнаружен ген пессимизма
Канадские ученые из Британской Колумбии доказали, что есть определенный разряд людей, которые генетически предрасположены к мрачным взглядам на жизнь. Их выводы по результатам исследования были опубликованы на страницах специализированного

Новогодний шопинг признан лучшим способом избавиться от лишних килограмм!
По мнению британских ученых ни одна диета не справляется с лишним весом эффективнее, быстрее и, что самое главное, приятнее, чем… новогодний шопинг. Если в другое время года долгие и частые походы по магазинам считаются болезнью (определенн
.jpg)
7 полезных советов, как справиться с бессонницей с помощью йоги
Бессонница – своеобразный тревожный звоночек, сигнализирующий о том, что какие-то вещи в жизни пора менять. Когда тело подсказывает: «Мне так плохо, что я даже спать не могу», надо ему помочь, а не забрасывать таблетками. Процесс сна отража

Синдром хронической усталости: как распознать болезнь
Хроническая усталость чаще всего поражает тех, кто энергичен, деловит, ответствен и удачлив. Согласно одной из теорий, многие из таких людей не жалеют себя, в результате чего снижается их сопротивляемость инфекциям и стрессам, которые влияю
Ученые повернули вспять старение клеток крови
Ученые из университета Ульма (Германия) сообщили, что обнаружили молекулярный переключатель в стволовых клетках крови, который может стать ключом к замедлению процессов старения. Это исследование, опубликованное 20 октября в журнале Nature,
.jpg)
Что делать, если никак не проходит кашель
Зимой эта напасть случается особенно часто – противный, изматывающий сухой кашель, который не даёт ни спать, ни работать. Как же лечить сухой кашель у взрослых, и откуда он берётся?
.jpg)
Храп опасен для здоровья. Лечения храпа в домашних условиях
Каковы причины храпа, чем он особенно опасен для здоровья и с чего начинать его лечение?

Засыпать правильно, спать сладко и просыпаться красавицей!
Примерно треть нашей жизни мы проводим во сне. Именно здоровый сон – источник бодрости, хорошего настроения и цветущего внешнего вида. Некачественный сон является одной из причин бледности кожи, кругов под глазами, потухшего взгляда, плохог

Недостаток углеводов может навредить здоровью
Споры относительно долговременных эффектов низкоуглеводных диет не стихают в ученой среде. Если брать во внимание быструю потерю в весе за короткий период времени, то подобные диеты довольно эффективны. Но у некоторых ученых возникают сомне

Квашеная капуста выводит токсины из организма
Своеобразной «метлой» для кишечника является клетчатка она содержится в свежих овощах и фруктах, злаках, отрубях и квашеной капусте. А ежедневное употребление яблок в течение месяца отлично порадует вас отражением в зеркале! Только тщательн

Причиной 50% случаев бесплодия - воспаление придатков
Женщина – создание нежное и, порой, чувствительное, поэтому для нее так важно беречь свое здоровье еще с молодости. Ведь она должна помнить, что ее роль на земле быть матерью. А причиной 50% случаев бесплодия - воспаление женских половых ор

Как быстро заснуть и выспаться за короткое время
На часах три утра, а вы все еще ворочаетесь с боку на бок. Опять. Дайте-ка угадаем: за это время вы успели придумать миллион хлестких ответов начальнику, несправедливо наехавшему на вас днем, или как минимум построили планы на ближайшую нед

Ученые объяснили, откуда у людей тяга к сладостям
Тяга к сладостям у большинства из нас наблюдается с детства. Сладкий вкус материнского молока — первый вкус, с которым знакомится новорожденный. Неудивительно, что конфеты, чизкейки, мармелад и сладкие булочки всю жизнь потом ассоциируются